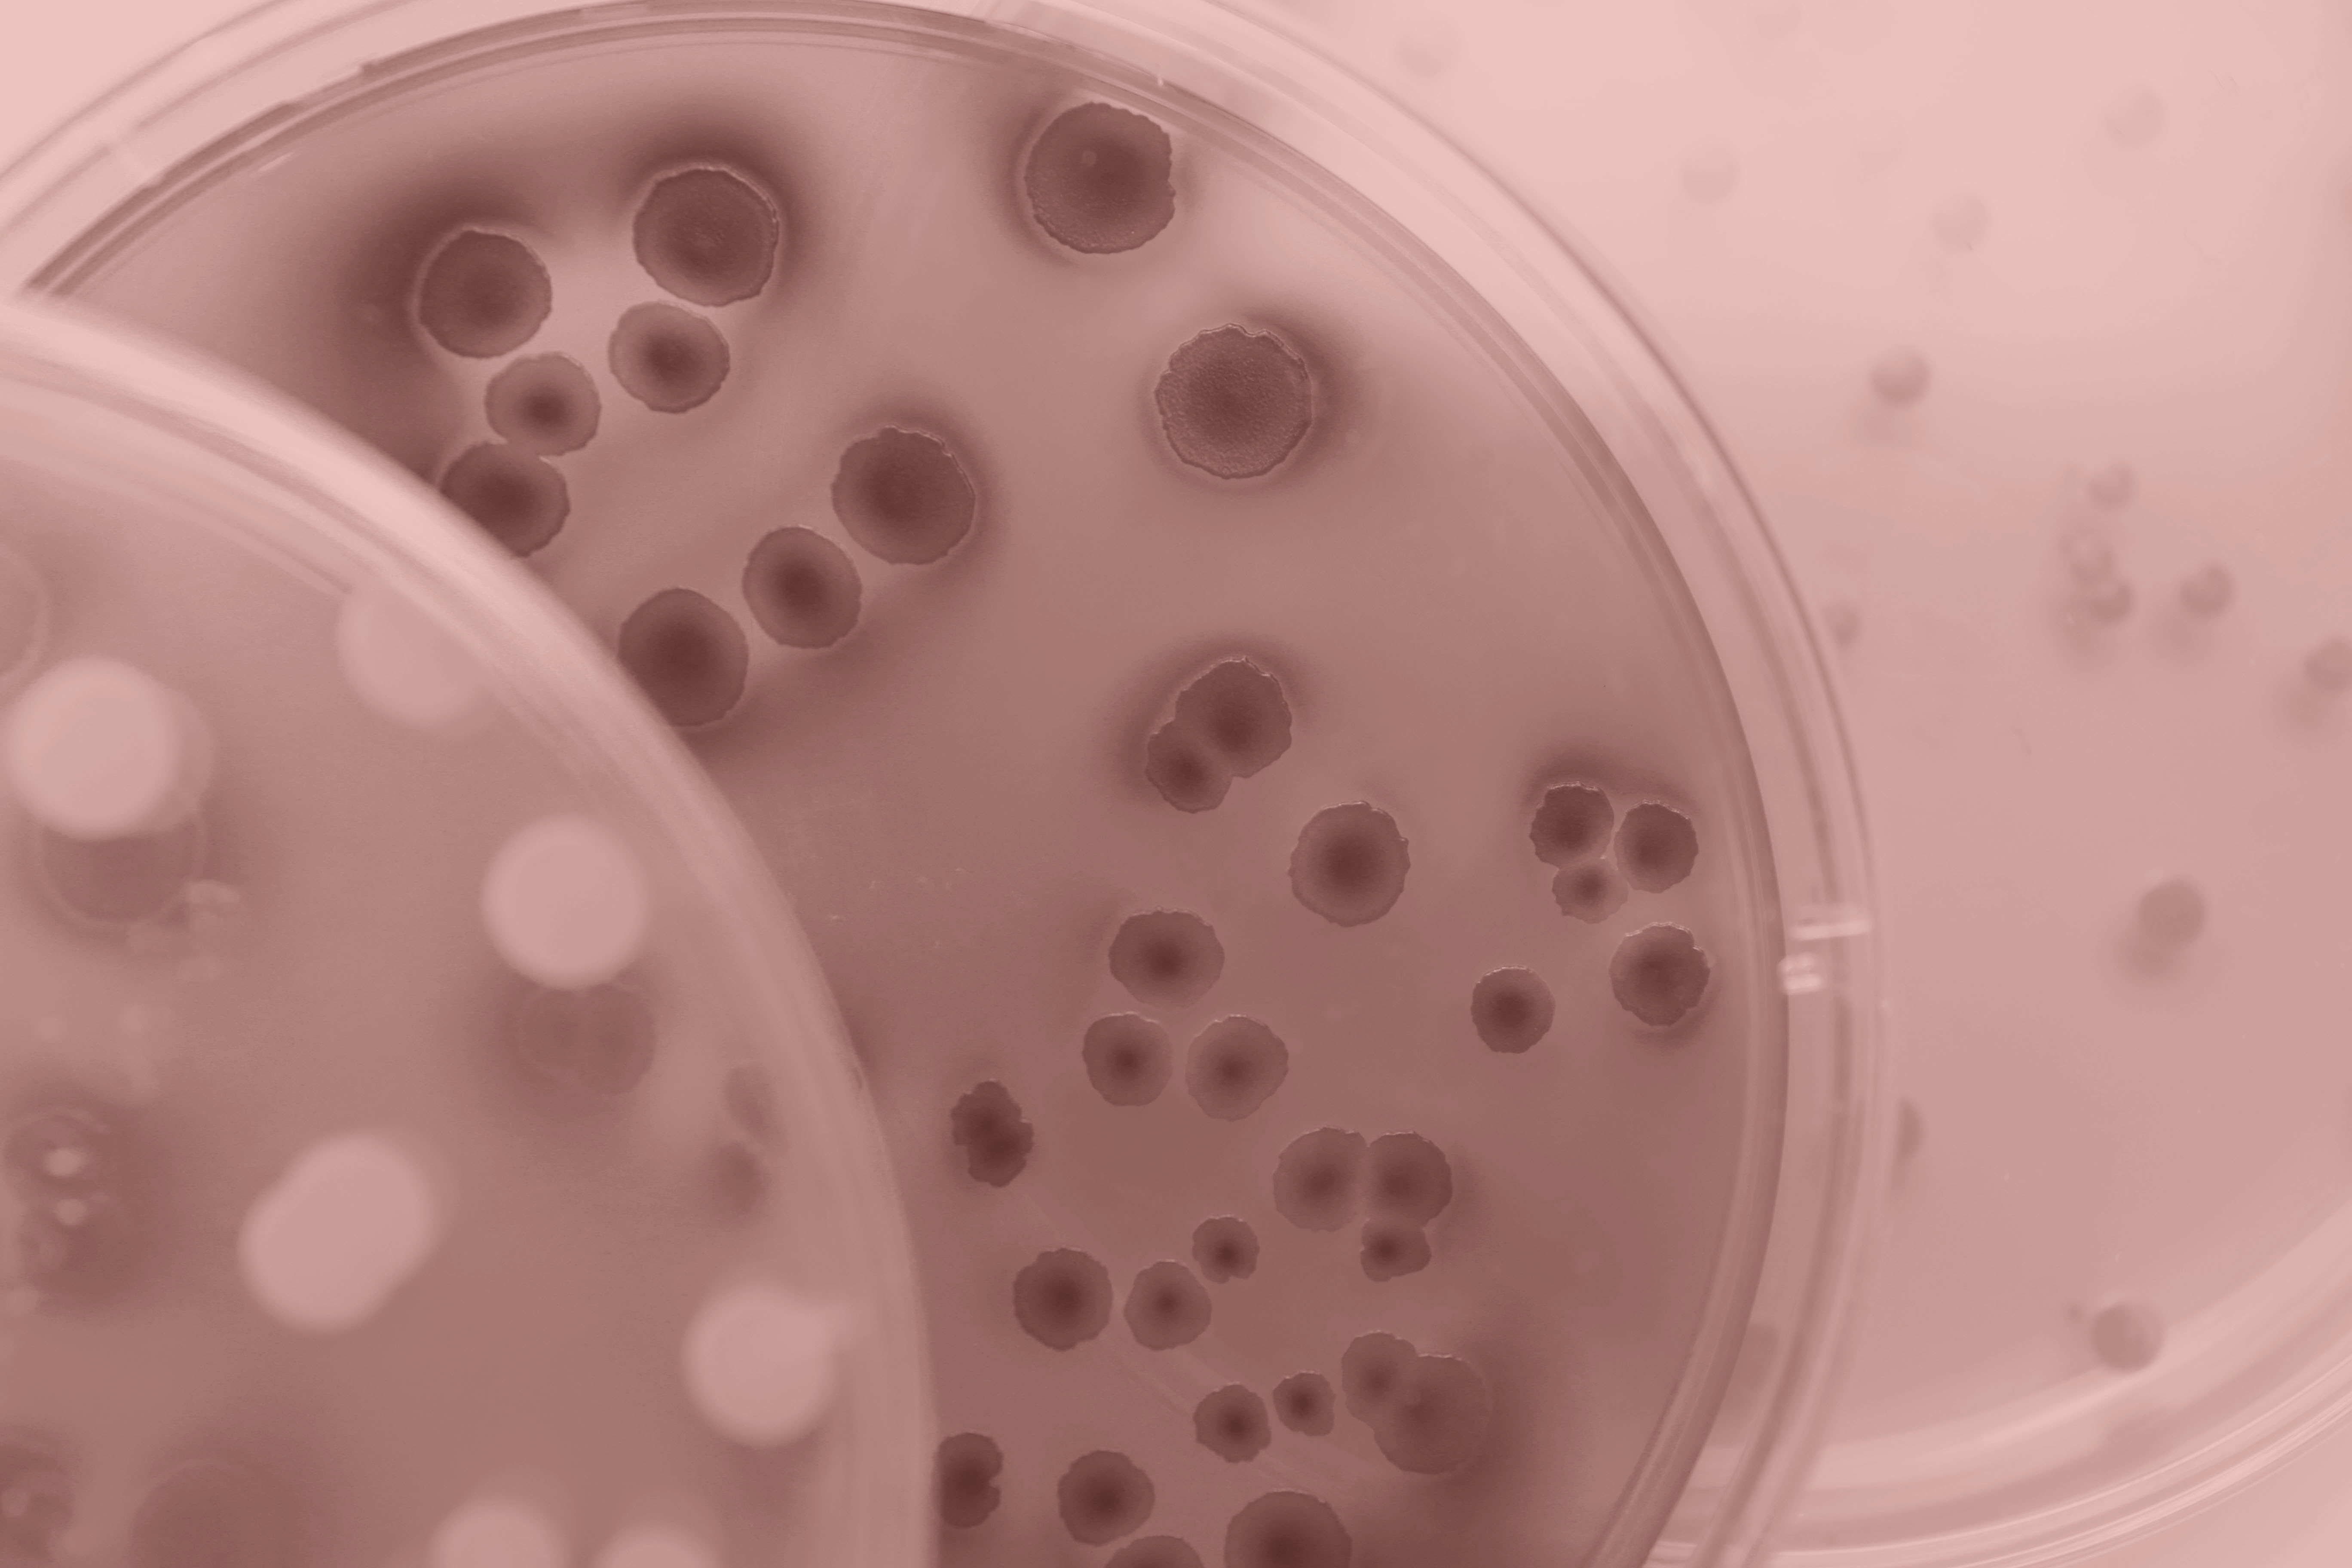
Three overlapping petri dishes with bacterial growth

When you purchase through link on our land site , we may earn an affiliate commission . Here ’s how it process .
In 2021 , a piece in his 50s was transferred to the intensive fear unit at Emory University Hospital in Atlanta . He wasin infected shockdue to a bacterial infection that had spread to his bloodstream . The culprit?Klebsiella pneumoniae , which wasresistant to most antibiotics .
Finally , hope emerged : A two - week course of an antibiotic calledcefiderocolseemed to empty the infection . But just 10 daytime after , the man was rushed back to the ICU , where doctors discovered a pus - occupy mass covering his liver . The same bacteria had returned with a retribution .

Scientists have found evidence for a new type of antibiotic resistance, known as heteroresistance, which isn’t detected on standard clinical tests. In it, a small proportion of bacteria in a population can evade antibiotics, but won’t become dominant until exposed to antibiotics.
The Doctor sent the affected role ’s stock sample distribution toDavid Weiss , a microbiologist at Emory Antibiotic Resistance Center . Weiss discovered that the bacteria were now highly resistant to cefiderocol .
He quickly give notice the medico . But even after throw antibiotics , the man die .
The man ’s case highlights an elusive strategy that bacteria apply in their arms race against antibiotic drug — a out of sight type of resistance that can be switched on almost instantly but leave no genetic trace . And it can be almost impossible to discover using stock lab tests . Researchers are increasingly recognizing that this bacterial strategy , called " heteroresistance , " may work a significant role in antibiotic failures . Recognizing this bacterial scheme , experts say , is the first whole step in fighting it .
Lab dishes showing different levels of bacterial growth. To detect heteroresistance, researchers must test bacteria on plates with both varying bacterial density and antibiotic concentration, meaning it could take hundreds of plates to find heteroresistant bacteria.
" While this is a worrisome phenomenon that we ’re studying now , in the bounteous scene and in the future , I cerebrate we ’ll be able to use this noesis to greatly avail patients , " Weiss told Live Science .
A new kind of resistance
For decennium , microbiologists like Weiss thought of antibiotic resistivity as something a bacterial species either had or did n’t have . But " now , we are realizing that that ’s not always the case , " he enjoin .
usually , genes determine how bacteria stand firm certain antibiotic drug . For example , bacteria could gain a gene mutation thatenables them to chemically disable antibiotics . In other cases , gene may code for protein thatprevent the drugs from cross bacterial cellular phone walls . But that isnot the case for heteroresistant bacterium ; they kill drugs designed to wipe out them without bona fide resistance genes . When they ’re not let out to an antibiotic , these bacterialooklike any other bacterium .
When distinctive antibiotic - insubordinate bacteria spread , they lead immunity gene to the next propagation , creating a legion of antibiotic - resistive populationsthat conjointly foresee the treatment . In contrast , bacterium in a heteroresistant universe aresensitive to antibiotic . But at certain disk operating system of an antibiotic drug , a pocket-size proportion of this population — as few as 1 in a million — may turn tolerant and survive the drug while the rest of the population block up growing and dies .

Antibiotics are typically chosen for patients based on standard clinical tests, which don’t detect heteroresistance. If scientists can find an easy way to test for it, patients could be given the appropriate medication from the start.
Because these immune cellular phone are interspersed with antibiotic - susceptible cells , it is difficult for microbiologists todetect the resistive ones .
Scientists across the globe have spend yearsinvestigatingwhy and how heteroresistance develops so they can get good at detecting these bacteria . Now , Modern clue are finally beginning to emerge .
Face-to-face with rogue bacteria
Karin Hjort ’s first encounter with heteroresistance happen by luck . About 10 years ago , Hjort , a microbiologist at Uppsala University in Sweden , was grow bacterium . Strain by stress , she administered lethal doses of antibiotics , label any survivor as " repellent " and freeze them . When she melt out the survivor , she searched for genetic changes , or mutations , that typically underlie their ability to chicane last .
But this time , when she lease out the seemingly resistant strain , she " sequenced them and sequence them " and " did n’t discover any mutations , " Hjort Live Science .
Hjort could n’t figure out what was happening . It seemed as if these bacterium had lost their resistance upon freezing . But then she discovered adecades - oldresearch paperdescribing a phenomenon scientist at the University of California , Davis called " heteroresistance , " in which a population of antibiotic - resistant bacteria could egress at an unusually quick rate from a seemingly susceptible population .

In fact , " heteroresistance " was firstmentioned back in the 1940s . But the phenomenon is very thought-provoking to learn , and without a clear definition , scientist scramble to equate their observation .
" Everyone call out ' heteroresistant ' in different ways — there was no standard to take care at,“Omar El - Halfawy , a microbiologist at the University of Regina in Canada , distinguish Live Science . Some peopleuse the termto describe a situation in which multiple types of bacterium with unlike antibiotic tolerance levels coinfect a person . Others use it to describe a scenario where two unlike antibiotic susceptibleness tests give dissimilar results .
set to settle the issue , in 2015 El - Halfawyreviewedevery subject field he could find that described heteroresistance . finally , he decide , heteroresistance appears when some fraction of a bacterial cultivation population can withstand a much high antibiotic concentration than the residuum of the population . Scientists adopted this definition in 2015 , and the identification number of peer - reviewed publications on heteroresistance has sincedoubled .

Fooling the test
The fraction of tolerant bacterium in a heteroresistant population can be anywhere from 1 in 1 million to 1 in 10,000 . It is so rarefied that stock clinical microbiology tests easilymiss it .
" Essentially , what you ’re trying to do is notice a insubordinate needle in a susceptible hayrick of cells , " Weiss say .
While bacterium often transition from being antibiotic - susceptible to antibiotic - insubordinate , this conversion usually occur in small increments andover at least several day . With heteroresistance , the changeover isalmost immediate .

The switch between susceptible to resistant and then back againconfuses test analyses .
" Every prison term you grow a strain , it ’s going to originate a niggling routine differently , " Weiss aver . " On one day , it might descend up as immune ; on the next Clarence Shepard Day Jr. , it might be susceptible . In fact , " sustain inconsistent , discrepant examination resolution was like a trademark of the strain being heteroresistant . "
The standardantibiotic susceptibleness testgoes like this : A population of bacteria , at a fixed concentration of about 10,000 to 100,000 mobile phone in a mil of broth , is dosed with dissimilar concentrations of an antibiotic drug until they stop procreate or die .

But , according to Hjort , this outgrowth is n’t designed to spot heteroresistance . Because these stock trial run only detect population - wide behavior , extremely rare phenomenon like heteroresistance will be missed . " The error is huge , even if we use more bacterium , " she said .
So far , the only method acting for spotting heteroresistance is calledpopulation analysis profiling(PAP ) . To perform this tryout , microbiologists uprise bacteria overnight , place some on a series of petri sweetheart containing unlike concentration of antibiotic drug , and supervise the bacteria ’s ontogenesis . Because spoon food covers a chain of bacterial densities , the test can pluck up pattern not normally detected by standard tests .
But the method acting is laborious , Hjort said . When supernumerary variables — such as the eccentric of antibiotic or the cellphone denseness — are tot to the equation , the phone number of dishes trio or quartet , saidSofia Jonsson , a graduate student at Uppsala University who work with Hjort .

" If you do a large experimentation , it can be 200 plates to consider , " and each plate may have hundreds of bacterial colonies to count , Jonsson told Live Science . Because it is so tedious , PAP is not routinely done in a clinical setting .
Weiss speculated that to find heteroresistance , succeeding tests would need to monitor bacterium at a individual - cell level and have a 1 - in-1 - million cell solvent . Someresearchis already making step in that direction , he said , but none of these developing have reached the clinic yet .
That ’s crucial , because with a rapid run , patients with heteroresistant bacterial contagion could be given the right medicines from the start , rather than make their illness worsen for years or hebdomad before doctors try drugs that function .

Cracking the case
Because heteroresistance occurs without permanent genetic mutations , Hjort ’s team want to have sex whether there were irregular change to the bacterial genome that could explain the phenomenon .
From Hjort ’s observance , two group of bacteria could have at least aneightfold differencein antibiotic leeway within a heteroresistant population . To figure out why , shetesteda handful of multidrug - tolerant strains of bacteria such asEscherichia coli , Salmonella enterica , K. pneumoniaeandAcinetobacter baumanniiagainst 28 antibiotics . These " gm - negative " bacteriahave an out membranethat shields them from toxic meaning . Not a single new class of antibiotic that point gram - electronegative bacterium has been sanction in thepast 50 days .
Using a whole - genome sequencing proficiency , Hjort and colleague found that some bacteria became heteroresistant because they temporarily made written matter of existing factor that assist themevade antibiotic drug .

to begin with this class , theyexpanded the studyto let in the Hans C. J. Gram - confirming bacteriumStaphylococcus aureusthat causes common skin infections . These bacterium have no outer membrane , and their ohmic resistance chemical mechanism are generally different from those of Hans C. J. Gram - negative strains .
Hjort and her teamtestedfor antibiotic immunity against 40 patient samples containingS. aureusthat were sequester from hospital affected role in Denmark , Norway , Spain and Sweden . stock trial suggested all of the bacterium could be handle with all six antibiotics .
However , the PAP result revealed heteroresistance to more than half of these antibiotic . These bacteria miss typical antibiotic resistance genes and had n’t made unwritten copies of factor that were protective as the gram - negative bacterium had .

Instead , heteroresistance correlated with chromosomal point mutations — change in individual radix pairs on various genes — that could be reversed if another variation happen . It ’s still unclear what these variation do and why heteroresistance seemed to come forth only against sealed drug .
But the variableness in how heteroresistance emerges , depend on the drug and species involved , suggests treatment approaches will need to be dissimilar , Hjort said .
The quest continues
— 10 of the deadliest superbug that scientist are worried about
— Bacteria that switch antibiotic ohmic resistance on and off are going undetected . Microbiologist Karin Hjort is on a mission to find out how they do it .
— What ’s the difference between gram - positive and gram - negative bacteria ?

Scientists have now reported bacterial heteroresistance against almost every class of antibiotics . Hjort cogitate a much magnanimous clinical dataset is needed to to the full understand the link between heteroresistance and patient outcomes .
A unspoiled means to bulge out , she said , is with a proper understanding of how these bacterium develop their heteroresistance in the first place .
Weiss agree .

By knowing the mechanism of action , " we may be able to get novel drugs that can reverse the heteroresistance and make the bacterium susceptible to the original drug , " he say . “It ’s always better to screw your enemy . "







